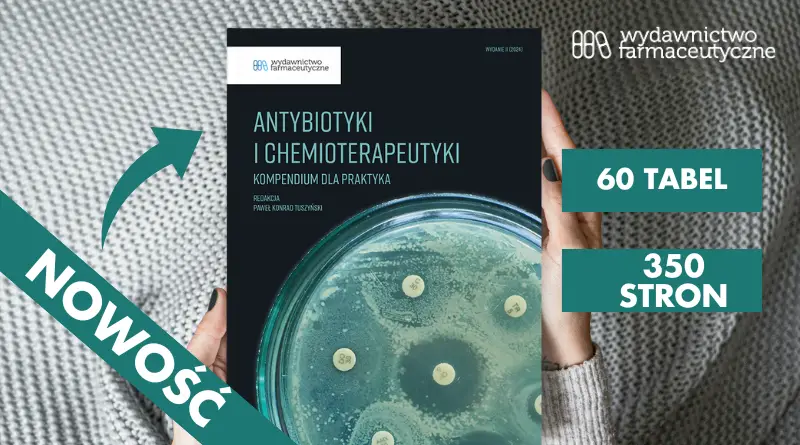
antybiotyki

Antybiotyki i chemioterapeutyki: Kompendium wiedzy dla praktyka – książka, której potrzebujesz!
Antybiotykoterapia stanowi nieodłączny element codziennej pracy każdego farmaceuty, lekarza oraz kluczowy obszar nauki dla studentów medycyny. Aby skutecznie pomagać pacjentom, potrzebujesz nie tylko aktualnej, ale również uporządkowanej wiedzy. To właśnie ona pozwala podejmować świadome decyzje terapeutyczne. „Antybiotyki i chemioterapeutyki: Kompendium wiedzy dla praktyka” powstało z myślą o tym, aby wesprzeć Cię w tym procesie.
Dlaczego ta książka jest niezbędna?
Publikacja nie jest tylko podręcznikiem, ale przede wszystkim wyjątkowym kompendium dedykowanym farmaceutom, lekarzom oraz studentom farmacji. Dzięki niej nie tylko uporządkujesz swoją wiedzę na temat antybiotyków i chemioterapeutyków, ale także ją zaktualizujesz. W czasach, gdy bakterie stają się coraz bardziej oporne na antybiotyki, a rekomendacje wciąż się zmieniają, kluczowe jest zrozumienie i znajomość aktualnych wytycznych. To one pozwalają na bezpieczne i skuteczne stosowanie leków przeciwbakteryjnych.
Co znajdziesz w książce?
Treść publikacji została podzielona na trzy główne części:
- Charakterystyka leków przeciwbakteryjnych – szczegółowo omawia grupy antybiotyków, ich mechanizmy działania oraz dostępne w Polsce preparaty. To idealna pomoc dla farmaceutów, którzy chcą lepiej zrozumieć dostępne produkty.
- Bezpieczeństwo stosowania antybiotyków – znajdziesz tu szczegółowe informacje dotyczące nadwrażliwości, przeciwwskazań oraz możliwych interakcji. Co więcej, publikacja zawiera rozdział o stosowaniu antybiotyków w ciąży oraz podczas antykoncepcji, co jest niezwykle istotne w praktyce.
- Praktyczne omówienie schorzeń infekcyjnych – książka oferuje zwięzłe opisy infekcji oraz tabele dawkowania antybiotyków, w tym ich nazwy handlowe. To znacznie ułatwi szybkie odnalezienie potrzebnych informacji i przyspieszy Twoją pracę.
Dla kogo jest ta książka?
- Farmaceuci zyskają uporządkowaną wiedzę i wsparcie, które przyda się w codziennej pracy, zwłaszcza przy wystawianiu recept farmaceutycznych.
- Lekarze znajdą w niej przegląd dostępnych preparatów oraz tabele dawkowania, co usprawni podejmowanie decyzji terapeutycznych.
- Studenci uzyskają solidne podstawy z zakresu mechanizmów działania antybiotyków, zagadnień dotyczących lekooporności oraz chemii leków. Wszystko to w przystępnej i zrozumiałej formie.
Dlaczego warto ją mieć?
Chociaż Charakterystyki Produktów Leczniczych (ChPL) są szeroko dostępne, często nie wystarczają, by w pełni zrozumieć zasady antybiotykoterapii. Producenci sami podkreślają, że „należy uwzględnić oficjalne wytyczne dotyczące właściwego stosowania leków przeciwbakteryjnych”. Dlatego właśnie powstała ta książka – zawiera ona nie tylko aktualne rekomendacje, ale także praktyczne porady, które pomogą w codziennej pracy.
Co nowego znajdziesz w tym wydaniu?
Nowa wersja podręcznika opiera się na monografii i została wzbogacona o:
- Więcej praktycznych aspektów stosowania antybiotyków i chemioterapeutyków, które usystematyzują Twoją wiedzę.
- Szczegółowe omówienie grup antybiotyków dostępnych w Polsce, a także aktualne wytyczne dotyczące terapii infekcji.
- Więcej stron przy zachowaniu podręcznego formatu.
Dodatkowo książka została zaprojektowana w sposób przejrzysty, z licznymi tabelami i zestawieniami leków, co znacznie ułatwia korzystanie z niej na co dzień.
Skorzystaj z przedsprzedaży!
Przedsprzedaż już ruszyła, a oto jej harmonogram:
- 30.09.2024 – 06.10.2024:
199 zł→ 149 zł - 07.10.2024 – 31.10.2024:
199 zł→ 169 zł
Nie czekaj – zamów teraz i zyskaj dostęp do najbardziej aktualnej wiedzy o antybiotykach! Więcej informacji znajdziesz tutaj.